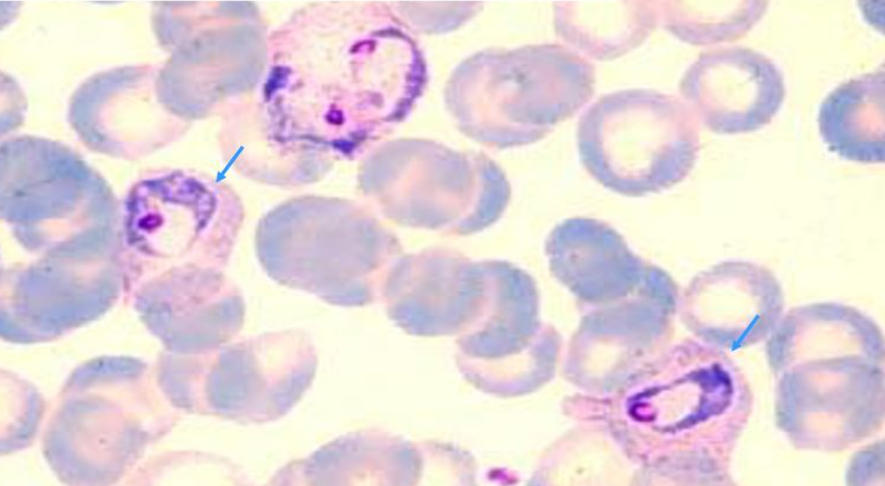

지난 8월 3일 국내 말라리아 경보가 발령된 사실을 포스팅한 적이 있다.
https://emdoc1988.tistory.com/121
말라리아 조심하세요~!!
★모기에서 말라리아 원충 확인, 말라리아 조심하세요! ★ □ 매개모기에서 삼일열말라리아 원충 감염 확인 □ 말라리아 위험지역 모기 방제 강화 필요 □ 말라리아 위험지역 거주 및 여행객은
emdoc1988.tistory.com
나는 현재 인천지역 2차병원 응급실에서 근무하고 있는데, 이번달 벌써 2번째 말라리아 환자를 만나게 되었다.
군의관시절 최전방 1사단 파주에서 복무했을 당시보다 말라리아 환자를 많이 보게 되는 것 같다.
군대에서는 오히려 말라리아 위험지역에서 근무할 경우 말라리아 예방 약을 복용시키고 있는데, 아마도 효과적으로 예방되었던 듯하다.
이번에 찾아보며 알게된 사실인데 2022년도 말라리아 관리지침이 새로 발행되었고, 이전과 약물 사용에 다소 차이가 있어 보여 이번 포스팅에선 간단히 말라리아의 진단 및 치료를 위주로 공부해보고자 한다.
#. 말라리아 위험요인
- 위험지역 : 인천광역시, 경기 북부, 강원 북부 지역에 거주 또는 방문한 병력이 있는 환자
- 해외 말라리아 위험지역의 여행 경력이 있는 경우
#. 말라리아 증상
- 말라리아는 규칙적인 발열 주기를 보이게 되므로, 환자의 발열 패턴을 확인하는 것이 필수적이다.
예를 들어, 매일 열이나고 몸살기운이 있는데, 2-3일 힘들다가 점차 좋아진다면 일반 감기몸살일 가능성이 높다. 하지만, 하루 열이 나고 힘들다가 1-2일은 또 살만하고, 다음날 다시 발열이 있다가 1-2일은 또 괜찮은 식의 발열 패턴이 전형적이다. 다만, 발열주기는 말라리아 원충의 종류에 따라 다를 수 있다. 우리나라에서 가장 흔한 삼일열 말라리아는 하루 열나고 하루 쉬고 하루 열나고 하루 쉬고 하는 식의 패턴을 보이는 게 일반적이다.
1) 삼일열 말라리아
- 권태감과 서서히 상승하는 발열이 초기에 수일간 지속된다.
- 48시간 주기로 오한, 고열, 발한 후 해열이 반복적으로 나타남
- 오한기 : 춥고 떨리는 시기, 글씨를 쓰기 힘들거나 치아가 떨려 말하기 힘들 정도의 심한 오한이 나타날 수 있으며 30분에서 2시간 정도 지속된다.
- 발열기 : 39도 이상의 고열이 나타나며, 심한 두통과 구토, 갈증이 생기며 수시간 지속된다.
- 발한기 : 침구나 옷을 적실 정도로 심하게 땀을 흘린 후 체온이 급격하게 정상화되면서 전신 무력감이 동반됨.
- 두통이나 구역, 설사 등을 동반할 수 있음.
2) 열대열 말라리아
- 초기 증상은 삼일열 말라리아와 비슷하나 열발작이 24시간, 36시간, 48시간 등 주기적이지 않은 경우도 많으며 오한, 기침, 설사 등의 증상이 나타난다.
- 중증이 되면 황달, 응고장애, 신부전, 간부전, 쇼크, 의식장애나 섬망, 혼수 등의 급성 뇌증이 동반될 수 있다.
- 신속한 치료가 예후에 결정적인 영향을 미치므로 진단 즉시 치료를 시작해야 한다.
3) 이외에도 난형열, 사일열, 원숭이열 말라리아 등이 있다.
#. 말라리아의 진단
- 추정진단 : 혈액에서 특이 항원을 검출하는 신속진단키트를 이용한다. 다만, 국내 말라리아 발생 빈도가 높지 않기 때문에 신속 진단키트를 보유하고 있는 병원은 매우 제한적이다. 필자가 근무하는 병원도 신속진단 키트는 따로 구비되어 있지 않다.
- 확인진단 : 현미경을 이용하여 도말된 말초혈액에서 말라리아 원충을 확인하거나 PCR, LAMP 등의 기술을 이용하여 말라리아 특이 유전자를 검출하는 방법이 사용된다.
- 삼일열말라리아의 영양형 단계
- thin blood smear, giemsa stain으로 확인
- 영양형 단계에서는 말라리아 원충의 형태가 "ameoboid form"으로 발육
- 감염 적혈구의 크기는 주변의 적혈구보다 팽대해진다.
- Schuffer's dot이 적혈구 표면에 출현한다.
#. 말라리아의 치료
| 구분 | 치료방법 |
| 국내 토착형 삼일열 | - 클로로퀸 3일 + 프라마퀸 14일 - 클로로퀸 감수성이 있으므로 클로로퀸을 사용하며, 재발방지를 위해 프라마퀸을 사용한다. - 재발 방지를 위한 프리마퀸은 클로로퀸과 동시 투여를 시작하거나 클로로퀸 치료 후 이어서 투여 할 수 있다. |
| 해외유입 말라리아 | - 메플로퀸 3일 + 프리마퀸 14일 - 아토바쿠온-프로구아닐 3일 + 프리마퀸 14일 - 피로나리딘-아르테스네이트 3일 + 프리마퀸 14일 |
| 중증말라리아 | - 아르테수네이트 주사제(Artesunate) |
1) 클로로퀸(chloroquine)
- 총 25mg/kg 용량을 3일에 나누어 경구로 투여한다.
- 현재 국내에는 하이드록시클로로퀸(hydroxychloroquine) 100mg, 200mg, 400mg 제품이 시판 중이며, 따라서 클로로퀸을 기준으로 용량을 변환하여 투약해야 한다.
- 클로로퀸 600mg = 하이드록시클로로퀸 800mg
- 용법 A : 첫날 10mg/kg, 2일째 10mg/kg, 3일째 5mg/kg를 투약
- 용법 B : 처날 10mg/kg 이후 6시간, 24시간, 48시간에 각각 5mg/kg를 투약
-> 예를 들어, 60kg 성인을 기준으로 처음 600mg의 클로로퀸을 복용해야 하는데, 이는 하이드록시클로로퀸 800mg과 같은 용량이다. 이후 24시간 뒤 하이드록시클로로퀸 800mg, 48시간 뒤 하이드록시클로로퀸 400mg을 복용하면 된다.
2) 메플로퀸(Mefloquine)
- 하루 20~25mg/Kg를 1회 또는 2~3회로 나누어 경구 투여
-> 60kg 성인을 기준으로 1200mg~1500mg의 메플로퀸을 복용해야 하므로, 메플로퀸 250mg 짜리 알약을 하루 5~6알 1-3회에 나눠서 복용하면 된다.
출처 : 2022년도 말라리아 관리지침, 질병관리본부

'공부방 > 기타' 카테고리의 다른 글
| 코피(Epistaxis) (0) | 2024.02.27 |
|---|---|
| 하루걸이? 말라리아에 걸리면 왜 열이 났다가 안났다가 하나요? (0) | 2023.08.13 |
| 빈혈(4), 거대적혈모구빈혈(megaloblastic anemia)- 비타민B12, 엽산 부족 (0) | 2023.08.05 |
| 말라리아 조심하세요~!! (0) | 2023.08.04 |
| 빈혈(5), 용혈성빈혈/재생불량성 빈혈 (0) | 2023.07.31 |